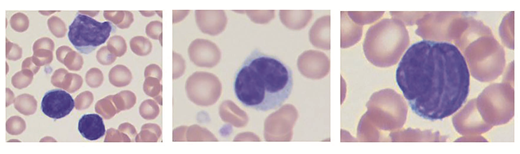
Figure 2

A 66-year-old man with extensive history of skin neoplasms including actinic keratosis, basal cell carcinoma, and low-stage melanoma presents to clinic with a persistent, pruritic, and irritated rash. He initially noticed redness on his head and face after he returned from a vacation in Florida, and it quickly spread throughout his torso, arms, and legs (Figure 1). He denies fevers, chills, fatigue, night sweats, or change in appetite or weight. He denies any new soaps, detergents, shampoos, or medications including over-the-counter supplements.
Positron emission tomography/computed tomography obtained four months after the first presentation demonstrated mild bilateral axillary and inguinal lymphadenopathy measuring up to 1.4 cm with maximal standardized uptake value of 2.9 cm. Complete blood counts are shown in the chart. Peripheral blood smear (Figure 2) showed circulating atypical cells. Additional flow cytometry was performed; the plots are depicted in Figure 3, with the population of interest marked in green. Although not shown, the cells of interest were negative for CD34 and TdT.
| Test . | Result . | Reference Range . |
|---|---|---|
| White blood cell count | 31.5 × 103/µL | 3.5-11.0 × 103/µL |
| Hemoglobin | 11.8 g/dL | 11.5-15.5 g/dL |
| Platelet count | 233 × 103/µL | 150-450 × 103/µL |
| Absolute neutrophil count | 4.88 × 103/µL | 1.12-6.72 × 103/µL |
| Absolute lymphocyte count | 2.99 × 103/µL | 0.9-3.30 × 103/µL |
| Manual Differential | ||
| Neutrophils | 16% | 39-75% |
| Lymphocytes | 10% | 16-47% |
| Monocytes | 2% | 4 - 12% |
| Eosinophils | 3% | 0-7% |
| Basophils | 1% | 0-2% |
| Myelocyte | 1% | 0% |
| Other cells | 67% | 0% |
| Test . | Result . | Reference Range . |
|---|---|---|
| White blood cell count | 31.5 × 103/µL | 3.5-11.0 × 103/µL |
| Hemoglobin | 11.8 g/dL | 11.5-15.5 g/dL |
| Platelet count | 233 × 103/µL | 150-450 × 103/µL |
| Absolute neutrophil count | 4.88 × 103/µL | 1.12-6.72 × 103/µL |
| Absolute lymphocyte count | 2.99 × 103/µL | 0.9-3.30 × 103/µL |
| Manual Differential | ||
| Neutrophils | 16% | 39-75% |
| Lymphocytes | 10% | 16-47% |
| Monocytes | 2% | 4 - 12% |
| Eosinophils | 3% | 0-7% |
| Basophils | 1% | 0-2% |
| Myelocyte | 1% | 0% |
| Other cells | 67% | 0% |
What is the diagnosis?
A. Follicular lymphoma
B. Pertussis related lymphocytosis
C. Sézary syndrome
D. T-lymphoblastic leukemia
To complete the quiz, visit https://ic.hematology.org/Thehematologist/Image-Challenge/12884901958.aspx.
Competing Interests
Dr. Takeda and Dr. Venkataraman indicated no relevant conflicts of interest.